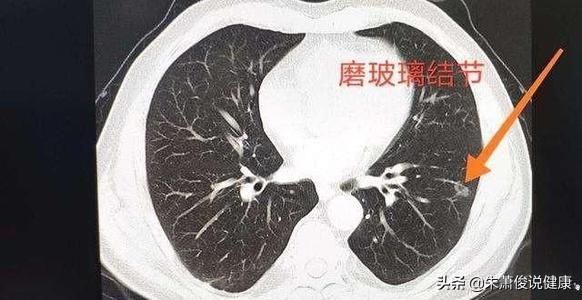

Wie groß ist ein Lungenknoten, der gefährlich ist?
Wie groß ist ein Lungenknoten, der gefährlich ist?
Lungenknoten sind kugelförmige Läsionen in der Lunge, die weniger als 3 cm groß sind. Mit dem weit verbreiteten Einsatz der Computertomographie der Brust bei medizinischen Untersuchungen wird die Entdeckungsrate von Lungenknoten immer höher, und viele Menschen haben sich auf Lungenknoten untersuchen lassen, ohne dass sie Beschwerden hatten, und sie haben Angst vor Lungenkrebs, wie es im Internet heißt, also wie groß sind die Knoten?
Knötchen werden in feste und gemahlene Glasknötchen unterteilt
Lungenknoten werden je nach ihrer Dichte in verschiedene Typen eingeteilt: Knoten mit höherer Dichte, die auf dem CT der Brust als weiße Punkte erscheinen, werden als solide Knoten bezeichnet, während Schliffknoten eine geringere Dichte haben und wie Wasserdampf auf dem Glas aussehen. Glasschliffknötchen, insbesondere reine Glasschliffknötchen, sind in der Regel bösartiger.
Die Gefahr eines Knötchens ergibt sich vielmehr aus der Tatsache, dass es sich
Im Allgemeinen spielt es keine Rolle, wie groß der Knoten ist, solange er sich nicht verändert. Natürlich ist die Wahrscheinlichkeit einer Veränderung umso größer, je größer der Knoten kurzfristig ist, und bei kleineren Knoten ist die Wahrscheinlichkeit einer Größenzunahme relativ gering. Unabhängig davon, ob es sich um einen Glasknollen oder einen festen Knoten handelt, ist es notwendig, bei einer Veränderung des Durchmessers im Rahmen einer Nachuntersuchung rechtzeitig zur Untersuchung und gegebenenfalls zur chirurgischen Entfernung ins Krankenhaus zu gehen.
Im Allgemeinen müssen Sie sich bei weniger als 6 mm nicht allzu viele Sorgen machen.
Im Allgemeinen sind Knötchen unter 6 mm eher gutartig. Einige Leute mögen sagen, dass bösartige Tumore nicht von 1 mm nach und nach wachsen. Hier gibt es ein Wahrscheinlichkeitsproblem. Im Allgemeinen sind gutartige Läsionen klein und stabil, die meisten von ihnen bleiben unter 6 mm, so dass die Wahrscheinlichkeit, entdeckt zu werden, wenn sie sehr klein sind, größer ist, während bösartige Tumore, insbesondere Lungenkrebs mit hohem Bösartigkeitsgrad, schneller wachsen, so dass es leicht ist, in einem größeren Stadium entdeckt zu werden. Knoten unter 6 mm können mit einer Wiederholungsuntersuchung des CT-Brustkorbs zum Zeitpunkt der ersten Entdeckung genau verfolgt werden, und das Intervall zwischen den Wiederholungsuntersuchungen kann in Zukunft schrittweise verlängert werden. Wenn sich keine Veränderung zeigt, kann das Intervall auf einmal pro Jahr verlängert werden.
Knötchen mit einem Durchmesser von mehr als 1 cm sollten weiter untersucht werden.
Knoten mit einem Durchmesser von mehr als 1 cm sind viel wahrscheinlicher bösartig als solche mit einem Durchmesser von weniger als 8 mm und müssen im Krankenhaus untersucht werden. Einerseits sind die Knoten zu klein, so dass ihre innere Beschaffenheit und ihre Zellaktivität nicht klar von den umgebenden Zellen unterschieden werden können und nicht-invasive Tests wie PETCT nicht in der Lage sind, sie zu identifizieren, und andererseits können invasive Tests wie Bronchoskopie und Lungenpunktion aufgrund ihrer geringen Größe keine genaue Probe gewinnen. Andererseits können invasive Tests wie die Bronchoskopie und die Lungenpunktion aufgrund der geringen Größe der Knoten keine genaue Probe gewinnen, so dass meist nur Maßnahmen ergriffen werden, wenn der Knoten mehr als 1 cm groß ist, was aber nicht bedeutet, dass Knoten unter 1 cm ignoriert werden können. Allgemein gesagt, wenn der Knoten mehr als 6 mm und weniger als 1 cm groß ist, sollte der Fall entweder engmaschig überwacht oder der Knoten chirurgisch entfernt werden, wenn er vergrößert ist und es keine andere Möglichkeit gibt, die Art des Knotens zu unterscheiden. Es gibt keine andere Möglichkeit, die Art des Knötchens effektiv zu unterscheiden.
Wie hoch ist die Heilungsrate nach einer Knötchenoperation?
Die Heilungsrate bei Lungenknoten, insbesondere bei Knoten, die kleiner als 1 cm sind, ist sehr hoch, sie liegt bei nahezu 100 Prozent, und in den meisten Fällen ist nach der chirurgischen Resektion nicht einmal eine Chemotherapie erforderlich. Die Heilungsrate für Knoten nimmt ab, wenn der Knoten wächst, und die Heilungsrate für Massen, die größer als 3 cm sind, sinkt auf weniger als 30 Prozent, und die meisten erfordern eine postoperative Chemotherapie.
Ich danke Ihnen! Im Allgemeinen ist es gefährlicher, wenn der Lungenknoten auf etwa drei Zentimeter oder mehr anwächst, aber das muss je nach der tatsächlichen Situation beurteilt werden. Drei Zentimeter sind nur ein Volumenwert, und es gibt auch verschiedene lange und kurze Durchmesser, je nach den Bedingungen der Messung.
Die Theorie besagt, dass jeder Mensch Lungenknötchen hat, daran gibt es keinen Zweifel, nur sind manche davon groß und manche klein.
Zunächst einmal müssen wir verstehen, wie Lungenknötchen gebildet werden. Es ist vor allem, weil der menschliche Körper in der kontinuierlichen Atmung Prozess kann einige Ruß, Partikel eingeatmet werden, und sogar einige Schleim trockenen Knoten, Kruste, in den kontinuierlichen Prozess der abnormen Material in der Bildung von Lungenknötchen gewickelt. Natürlich kann es auch einige Krebszellen, die allmählich wachsen und sich vermehren, um Lungenknötchen zu bilden.
Wenn man also versteht, wie Lungenknötchen entstehen, versteht man auch, warum Menschen, die rauchen oder mit Staub arbeiten, dazu neigen, Lungenknötchen zu bekommen, die sich später zu Krebs entwickeln. Dann ist auch klar, wie die Knötchen in den späteren Stadien wachsen. Wenn die Knötchen in einem risikoreichen Beruf entstehen oder wenn die Person weiterhin unmäßig raucht, werden sie später auf jeden Fall größer und größer und entwickeln sich schließlich zu echtem Krebsgewebe.
Zweitens wird sein Wachstum durch eine Reihe von Faktoren bestimmt, zum einen durch die Exposition gegenüber einer Vielzahl von Risikostoffen wie Rauch, Staubpartikeln usw., zum anderen durch die Bildung von eigenem Tumorgewebe, das sich weiter vermehrt und differenziert. Schließlich wird er größer und größer werden.
Schließlich ist klar, dass bei Erreichen eines bestimmten Wertes eine hohe Wahrscheinlichkeit besteht, dass sich die Läsion von einer gutartigen in eine bösartige Läsion verwandelt oder sogar die bereits bösartige Läsion auf einen bestimmten Wert anwächst. Theoretisch liegt der Wert bei drei Zentimetern, aber in der klinischen Praxis können bereits zwei Zentimeter bösartig werden, was nicht ignoriert werden sollte. Und muss auch einen Grund zu verstehen, ist sein Niveau, nur in einer Ebene der Dreharbeiten Wirkung, gibt es Intervalle in der Mitte, wie ein Messer geschnitten Fleisch, und seine horizontalen Durchmesser und vertikalen Durchmesser ist manchmal völlig unpassend. Daher muss dies zu einem späteren Zeitpunkt mehrmals überprüft werden, basierend auf einer umfassenden Beurteilung, um die Diagnose schließlich zu bestätigen.
Und man muss sich auch bewusst sein, dass der Grad nur ein Aspekt des Faktors ist, es gibt einige andere Aspekte, die ihn auch bestimmen, und er könnte bösartig sein.
Er kann zum Beispiel klettenartig sein und eine unregelmäßige runde oder ovale Form haben. Es ist zum Beispiel möglich, dass er Verwachsungen mit dem Rippenfell hat, vor allem, wenn es bestimmte Anzeichen einer Verhärtung gibt, dann kann dies auch darauf hinweisen, dass es sich um einen bösartigen Tumor handelt.
Daher ist in der Klinik, nicht nur auf einen Indikator verlassen, um den Zustand zu bewerten, muss eine Kombination aus allen Aspekten der Situation zu bewerten, um eine klarere Behandlungsplan und Änderungen in der Situation haben. Es wird empfohlen, die Beurteilung einem professionellen Arzt zu überlassen, was der Gesamtbehandlung förderlicher ist.
Ich hoffe, dass alle bei guter Gesundheit sind!
Zunächst einmal ist die Entstehung des medizinischen Begriffs Lungenknötchen durch die Entwicklung der medizinischen Bildgebung begleitet und die Entstehung der so genannten medizinischen Bildgebung ist mit der Entwicklung von Wissenschaft und Technik und die Erfindung von medizinischen Geräten, und die Verwendung dieser Inspektionsgeräte durch die Untersuchung des menschlichen Körpers, und schließlich erlauben unseren Augen, um die innere Struktur unseres Körpers zu sehen, wie "Schatten" oder "wie", um die Kommunikation zu erleichtern, diese "Schatten" oder "wie" ausdrucken, die gemeinhin als "Schatten" oder "wie" bekannt ist. "oder" wie "zur Erleichterung der Kommunikation, die" Schatten "oder" wie "ausdrucken, das heißt, das gemeine Volk gemeinhin als die" Film "," zur Erleichterung der Kommunikation, die" Schatten "oder" wie "ausdrucken, das heißt, das gemeine Volk gemeinhin als die" Film ". "Film".

In der Tat sind diese Filme die Träger solcher Bilder, die für die Menschen bequem zu tragen sind, und erleichtern auch die Kommunikation zwischen dem Arzt und dem Arzt während des Besuchs, sowie die Kommunikation zwischen dem Arzt und dem Arzt während der Konsultation. So ist der erste ist der Röntgenfilm, und dann die Entwicklung der Medizintechnik, gibt es CT, Ultraschall, Endoskopie, Kernspintomographie, PET-CT und andere Untersuchungsgeräte, auch in einer Vielzahl von Untersuchungsbildern erschienen. Verschiedene bildgebende Geräte haben ihre eigenen unterschiedlichen Vor- und Nachteile, für die Lunge, jetzt Blick auf die interne Feinstruktur der Lunge deutlich ist die CT, ist die CT-Ausrüstung ist auch mit dem Fortschritt der sozialen Wissenschaft und Technologie Upgrades und Upgrades, 64 Zeilen, 128 Zeilen, 256 Zeilen erschienen sind, desto mehr fortschrittliche Technologie, desto kürzer die Scanzeit, Scan-Bereich, Scannen der Dicke der dünner, die Menge der erhaltenen Informationen mehr Informationen, um zu überprüfen, die subtilen Läsionen, sondern auch die fortschrittliche Technologie, Scannen der Scanzeit, Scannen der Scan-Bereich, Scannen der Dicke der dünner, mehr Informationen können überprüfen, die Je fortschrittlicher die Technologie, je kürzer die Scanzeit, je größer der Scanbereich, je dünner die Scandicke, desto mehr Informationen erhalten, desto mehr subtile Läsionen können erkannt werden. Daher gibt es viele subtile Läsionen, die mit einem Röntgenfilm nicht erkannt werden können, mit der CT aber schon.

Wenn man dies weiß, ist es klar, dass Lungenknoten das erste Wort ist, das in der Abteilung für medizinische Bildgebung in den Krankenhausabteilungen fällt. Anhand des Schattens oder des Fotos werden die Krankenhausärzte ihre eigenen Erfahrungen (aus Lehrbüchern und der klinischen Fallverfolgung) nutzen, um zu spekulieren, was den Schatten verursacht hat und welche Krankheiten die gleiche Art von Schatten verursachen können. Es ist dasselbe wie bei der Polizei, die einen Mordfall aufklärt und anhand der Fußabdrücke am Tatort analysiert, wer am ehesten der Täter sein könnte.

Wir kennen diese Vorstellung von der Diagnose der Krankheit, und dann gehen wir zurück zum Kopf, um über Lungenknoten zu sprechen. Lungenknoten sind runde oder unregelmäßige Läsionen mit einem Durchmesser von höchstens 3 cm in der Lunge, die in der Bildgebung als Schatten mit erhöhter Dichte erscheinen, die homogen oder inhomogen sein können, die einzeln oder mehrfach vorkommen können und die klare oder unklare Grenzen haben können.

Wir wissen, dass die Mentalität des einfachen Volkes Angst davor hat, Krebs zu erwähnen, deshalb gibt es das Wort "Krebs". Krebs ist auch eine kleine bis große Krankheit, und wir alle wollen die Gefahr in der Wiege in der kleinsten Zeit töten, genau wie wir, wenn wir wissen, dass dieses Kind zu einer Gefahr für die Gesellschaft, zu einem Mörder oder einem Triadenmitglied heranwachsen wird, würden wir es lieber nicht zur Welt bringen, oder wie einige alte Leute sagen: "Wenn ich gewusst hätte, dass du so werden würdest, könnte ich dich genauso gut zu Tode würgen". Es wäre besser, ihn nicht zu gebären, oder wie manche alte Leute sagen: "Wenn ich gewusst hätte, dass du so werden würdest, hätte ich dich genauso gut erwürgen können." Das Problem ist, dass die Möglichkeiten der Zukunft umso vielfältiger sind, je jünger das Kind ist, und deshalb gibt es alle Arten von Menschen in der Gesellschaft. Kann man das im Sinne des Fragestellers interpretieren, wenn man es sich zu eigen macht, wie groß ein Kind wird, das eine Gefahr für die Gesellschaft darstellt? Das ist eigentlich das Gleiche.

Kinder Wachstumsprozess, einige kleine Zeit kann es gut sein, aber aufwachsen, um die Gesellschaft zu schaden, einige Kinder kleine Zeit kann es frech sein, aber aufwachsen, um nützlich zu sein, um die Gemeinschaft, einige Zeit, um zur Schule zu gehen oder die Menschen sehen, gute Kinder, aber absolvierte kann aufgrund einer Reihe von Faktoren, um die Nutzung ihrer eigenen erlernten Beruf, um Dinge zu schaffen, um die Gemeinschaft zu schaden, wie der frühere Bericht über die Nutzung der Kenntnisse des Studiums der Chemie, um Methamphetamin und anderen Schaden für die Gemeinschaft zu schaffen. Gesellschaft. Es ist also schwer zu sagen, in welchem Alter sie am gefährlichsten werden. Es gibt jedoch ein allgemeines Sprichwort, das besagt, dass man erkennt, wenn ein Kind drei Jahre alt ist", d. h. es handelt sich um Erfahrung, und die meisten Kinder erkennen das noch, woran? Am Verhalten des Kindes, an den Gewohnheiten des Kindes. Wenn das Kind klein ist, ist es nicht mehr böse und frech, und dann Unfug, sein Schaden ist auch sehr klein, mit dem Alter des Wachstums, hat das staatliche Gesetz 14 Jahre alt, 16 Jahre alt und der Erwachsene 18 Jahre alt, die Bestimmungen der rechtlichen Verantwortung ist nicht das gleiche.

Auch bei Lungenknoten wird im Allgemeinen eine dynamische Nachbeobachtung für Knoten unter 8 mm empfohlen, auch weil sie relativ wenig schädlich sind. Wenn jedoch Anzeichen für eine Bösartigkeit auftreten, ist es nicht einfach zu sagen, ob der Knoten beispielsweise in alle Richtungen unterschiedlich schnell wächst, ob er lobulär wird oder ob umliegende Grate auftreten (das Kind, das die Regeln befolgt, macht plötzlich wiederholt Fehler und läuft Amok).

Oder es verursacht eine Invasion der peripheren Pleura (Schädigung der Interessen der umliegenden Nachbarn), oder wächst sehr schnell in kurzer Zeit (wie ein Dieb, der häufige Verbrechen, Diebstähle und Raubüberfälle begeht), usw. All dies sind Hinweise auf bösartige Veränderungen. Diese 8 mm sind das Alter der rebellischen Kinder, aber auch die schwierigste Zeit, um sie zu disziplinieren, so dass die Eltern den heranwachsenden Kindern große Aufmerksamkeit schenken sollten, mehr Kommunikation, mehr Kommunikation, für 8 mm große Knoten, aber auch mehr Follow-up, mehr Beobachtung.

Einige Kinder werden ihre Adoleszenz friedlich zu verbringen, genau wie die Lungenknötchen dynamische Beobachtung ohne viel Veränderung, einige Kinder jugendlichen ideologischen Veränderungen, und um die Freunde, die Umwelt hat eine große Veränderung, die Lungenknötchen sind auch, wenn die Lungenknötchen in der Umwelt befindet sich die Umwelt des Immunsystems ist niedrig, ist eine trockene Umgebung wird anfällig für bösartige Veränderungen, weil die traditionelle chinesische Medizin, "Yin Ping Yang Geheimnis, den Geist der Heilung! "Lungen wie feucht und böse Trockenheit", "traurige Lunge", so dass der Schlaf zu verbessern, zu kultivieren positive und glückliche Gefühle, Selbstbefriedigung, kultivieren Gefühl, oder mit anderen, "die Freude der Menge! ", weg von der Traurigkeit ist die beste Belohnung für die Lunge; nicht rauchen, Rauch mit Feuer, kann die feuchte Umgebung wird trocken, für die Luftröhre und Bronchien, kann die Flimmerhärchen Swing-Funktion zu erhalten, ist förderlich für die Entlastung von Schleim und Stoffwechselprodukte in der Lunge sowie ausländische Schadstoffe, weg von der Staub, weg von Luftverschmutzung, Braten Zeit, um die Dunstabzugshaube öffnen sind sehr notwendige Maßnahmen.

Das Gleiche gilt für alle Knötchen über 8 mm, die dynamisch beobachtet werden müssen, um festzustellen, ob kurzfristig Anzeichen von Bösartigkeit auftreten, und wenn ja, müssen frühzeitige Maßnahmen wie eine Operation ergriffen werden. Wenn es keine Veränderung gibt, kann man nachfassen und beobachten. Dies ist nur eine allgemeine Erfahrung: Manchmal sieht es aus wie bösartige Anzeichen, aber die Operation ist gutartig, und manchmal sieht es gutartig aus, aber die Operation ist bösartig. So wie manche Menschen lange kämpfen, aber nie andere gefährden, nie die Gesellschaft gefährden, viele gute Dinge tun; manche Menschen sehen ganz gut aus, aber insgeheim tun sie Dinge, die die Gesellschaft gefährden, wie z.B. die Korruption mancher Leute abklopfen, mit dem Fahrrad zur Arbeit fahren, wer kennt schon die Veruntreuung von ein paar hundert Millionen, nicht gut zu sagen.

So ist es auch mit den Lungenknötchen, was ich oben gesagt habe, ist die Wahrscheinlichkeit. Aber eines ist richtig, ein gutes Umfeld kann eine Person verändern, ein schlechtes Umfeld kann eine Person beeinträchtigen, also ist es definitiv richtig, sich von schlechten Gewohnheiten fernzuhalten und nicht zu rauchen, und es ist richtig, irrationale Gewohnheiten zu korrigieren und die Immunität zu verbessern.
Knoten in der Lunge sind im Allgemeinen umso weniger wahrscheinlich bösartig, je kleiner der Knoten ist.
In der chinesischen medizinischen Leitlinie heißt es zur Definition des Lungenknotens: Die Bildgebung (Thorax-CT) zeigt einen fokalen, rundlichen, festen oder subsoliden Lungenschatten mit einer erhöhten Dichte und einem Durchmesser von ≤3 cm, der isoliert oder mehrfach vorhanden sein kann und nicht von einer pulmonalen Atelektase, einer Vergrößerung der hilären Lymphknoten und einem Pleuraerguss begleitet ist.
Im Allgemeinen wird jeder Schatten mit erhöhter Dichte in der Lunge mit einem Durchmesser von weniger als 3 cm als Lungenknoten bezeichnet, und der Grad des Risikos hängt nicht nur von der Größe ab, sondern muss auch in Verbindung mit der Morphologie, der Dichte und der Geschwindigkeit der Vermehrung des Knotens bestimmt werden.
Im Allgemeinen müssen Knötchen mit einem Durchmesser von mehr als 8 mm genau beobachtet werden, insbesondere wenn sie unregelmäßig geformt sind oder sogar von einem gratartigen Muster begleitet werden oder mit Leere vermischt sind, an die Pleura angrenzen und als pleurale Vertiefungen erscheinen, sollten wir sehr wachsam auf die Möglichkeit einer Bösartigkeit sein. Falls erforderlich, ist eine Punktionsbiopsie oder eine direkte Exzision erforderlich.
Bei Knötchen von weniger als 8 mm, insbesondere bei solchen von weniger als 6 mm, kann eine genaue Beobachtung und Überprüfung in Betracht gezogen werden: Die meisten der folgenden Bedingungen sind gutartig, wie z. B.: signifikante Veränderungen der Merkmale des Knötchens in einem kurzen Zeitraum, wobei die Ränder glatt oder unscharf werden, ohne Läppchenbildung; die Dichte des Knötchens ist einheitlich oder verblasst; und das Knötchen schrumpft oder verschwindet ohne Zunahme der Dichte.
Eine Bösartigkeit wird meist in Betracht gezogen, wenn folgende Veränderungen auftreten: eine allmähliche Zunahme des Knötchendurchmessers mit einer kurzen Verdopplungszeit; das Vorhandensein einer festen Komponente in der knotigen Läsion; oder das Vorhandensein einer festen Komponente oder eine Zunahme der festen Komponente in der knotigen Läsion, obwohl die knotige Läsion schrumpft.
Zusammenfassend lässt sich sagen, dass die Größe ein wichtiger Faktor bei der Bestimmung der Gutartigkeit oder Bösartigkeit eines Knotens ist, aber auch anhand anderer bildgebender Merkmale bestimmt werden muss.

Schauen wir uns zunächst eine Zahl an! Von den 8.200 Personen, die in das medizinische Untersuchungszentrum eines Zentralkrankenhauses aufgenommen wurden, lag die Zahl der Männer mit Lungenknoten bei etwa 1.500, mit einer Entdeckungsrate von 16 Prozent, und die Zahl der Frauen mit Lungenknoten bei etwa 1.700, mit einer Entdeckungsrate von 21 Prozent.
Das Brustbild kann nicht nur Lungenknötchen auffinden, sondern zeigt auch deutlich die Lage, Größe, Form und Merkmale der Knötchen, was darauf hindeutet, dass sich die Lungenknötchen in der Lunge befinden und sich dort angesammelt und gebildet haben, was im Einklang mit der chinesischen medizinischen Bezeichnung "Lungenstagnation", "Stagnation" und "Schleimkerne" steht und eine Grundlage für die Identifizierung der Krankheit in der traditionellen chinesischen Medizin bietet. Sie steht im Einklang mit der chinesischen Medizin "Lungenstagnation", "Stagnation" und "Schleimkerne" und bildet die Grundlage für die Identifizierung von Lungenknötchen in der chinesischen Medizin.
Tuberkulose
Charakteristische klinische Merkmale der Knötchenkrankheit 30-50 % der Patienten mit Knötchenkrankheit können Atembeschwerden und 18-51 % können Dyspnoe aufweisen. Bei der Mehrzahl der Patienten mit knotiger Erkrankung treten subakute oder chronische Symptome auf, während bei einer Minderheit der Patienten akute Symptome wie eine bilaterale Vergrößerung der hilären Lymphknoten, Arthritis und Erythema nodosum mit Fieber und Myalgie auftreten.

Zu den Anzeichen für einen hohen Grad an Knötchenbildung gehören Lupus, Uveitis, Sehnervenentzündung und Erythema nodosum; zu den Anzeichen, die auf eine mögliche Diagnose von Knötchenbildung hindeuten, gehören purpurrote Hautläsionen, subkutane Knötchen, Skleritis, Retinitis, geschwollene Tränendrüsen, granulomatöse Läsionen bei direkter Biopsie durch Laryngoskopie, symmetrische Vergrößerung der Ohrspeicheldrüsen und Hepatosplenomegalie.
Je nach Größe der Knoten werden sie in <5 mm, 5-10 mm und >10 mm eingeteilt, und je nach Lage werden sie als mit dem Rippenfell verbundene Knoten, periphere Knoten, hiläre Knoten und zentrale Knoten klassifiziert. Zu den gutartigen Läsionen gehören Entzündungen, Granulome, Ödeme, fokale Blutungen, Faserknötchen usw., während die häufigste bösartige Läsion das Adenokarzinom der Lunge ist.
Das gefährlichste Adenokarzinom der Lunge
Das Adenokarzinom der Lunge hat inzwischen das Plattenepithelkarzinom der Lunge als häufigste bösartige Erkrankung der Lunge abgelöst, wobei die Prävalenz bei Frauen und die Zahl der jüngeren Patienten zunimmt.
Das Adenokarzinom der Lunge ist reif für schnelles Wachstum und Metastasierung überall. Die alveoläre begrenzte Hyperplasie nimmt an Dichte zu und ist in der Regel weniger als 5 mm groß, wobei einige wenige größer als 10 mm sind.
Bei einigen Patienten entwickeln sich die Knötchen zu einem Carcinoma in situ weiter, bei anderen bleiben die Knötchen unverändert und entwickeln sich nicht weiter. Wenn das Knötchen weiter fortschreitet, wird es krebsartig, aber die Krebszellen sind alle auf die Alveolenhöhle beschränkt und aggregieren nicht. Er ist in der Regel größer als 5 mm und hat etwas an Dichte gewonnen.

Im weiteren Verlauf wachsen die Tumorzellen weiter und durchbrechen die Alveole, was als mikroinfiltrierendes Adenokarzinom bezeichnet wird. Der gesamte Körper des Adenokarzinoms weist die vollständige Struktur des Tumors auf, aber die interstitielle und vaskuläre Infiltration beträgt weniger als 5 mm. zu diesem Zeitpunkt der Resektion liegt die Überlebensrate ebenfalls bei nahezu 100 %.
Wenn es sich weiter entwickelt und follikuläre, papilläre oder mikropapilläre Strukturen mit einem Durchmesser von mehr als 5 mm bildet, spricht man von einem invasiven Adenokarzinom oder einem Adenokarzinom der Lunge. Erst dann wird es gefährlich!
Ich bin Apothekerin Lee und möchte Ihnen helfen, mit Ihrem Körper umzugehen, indem ich Ihnen komplexes und schwieriges Wissen über Krankheiten in einfachen Worten erkläre. Ihr Lob ist meine größte Motivation! Wenn Sie Familienmitglieder haben, die an ähnlichen Problemen leiden, leiten Sie diesen Artikel bitte an sie weiter!
Vor der CT-Untersuchung lag die Wahrscheinlichkeit, einen Lungenknoten zu entdecken, bei weniger als 0,2 %, und die Größe des gefundenen Knotens betrug in der Regel mehr als 1 cm. Mit der Verbreitung der CT-Untersuchung hat sich die Wahrscheinlichkeit, einen Lungenknoten zu entdecken, drastisch erhöht, aber die Frage, wie groß oder welche Art von Lungenknoten gefährlicher ist, ist derzeit ein besonders wichtiges Thema.
Im Folgenden zeige ich Ihnen, wie Sie das Verhältnis zwischen der Größe eines Lungenknotens und dem Risiko, dass er gut- oder bösartig ist, erkennen können!
Erstens werden bei der Einteilung der Lungenknötchen derzeit Lungenknötchen ≥8 mm und ≤3 cm als typische Lungenknötchen bezeichnet, während nur Lungenknötchen <8 mm als kleine Knötchen bezeichnet werden!
Derzeit, obwohl wir sagen, dass mit der kontinuierlichen Anwendung von Spiral-CT, ist es wahr, dass mehr und mehr Lungenknoten <1cm gefunden wurden, aber die Diagnose von solchen kleinen Knoten ist begrenzt, und es ist schwierig, zwischen gutartigen und bösartigen durch die aktuelle diagnostische Mittel zu unterscheiden, und die klinische Verwendung von bildgebenden Mitteln der regelmäßigen Beobachtung ihrer Veränderungen als die wichtigste Behandlung, und im Vergleich mit den typischen Lungenknoten, in unserer Klinik, die Behandlung wird aktiver!
Zweitens gibt es einen Zusammenhang zwischen der Größe des Lungenknotens und dem Grad des Risikos, dass er gut- oder bösartig ist! Im Allgemeinen geht man davon aus, dass Lungenknoten <5mm eine 0-1%ige Chance haben, bösartig zu sein; 5-10mm haben eine 6-28%ige Chance, bösartig zu sein; und >20mm haben eine höhere Wahrscheinlichkeit, bösartig zu sein, fast 60% oder mehr, was dem Grad der Bösartigkeit von mattglasartigen Lungenknoten entspricht!
Natürlich gibt es viele Möglichkeiten, die Gutartigkeit oder Bösartigkeit eines Lungenknotens festzustellen!
Erstens ist der Grad der Bösartigkeit höher, wenn ein Knoten morphologisch einen Grat oder einen lobulierten Rand zu haben scheint;
Zweitens, die Wachstumsrate Zeit, allgemeine Knötchen für mehr als ein Jahr beobachtet, keine offensichtliche Vermehrung Phänomen, gutartige Möglichkeit, aber mit Ausnahme von Milchglas-ähnliche Knötchen, muss weiterverfolgt werden und für mehr als 2 Jahre beobachtet;
Drittens gibt es natürlich bildgebende Verfahren, um dies festzustellen, z. B. dynamisch verstärkte CT- und PET-CT-Verfahren, aber auch hier gibt es blinde Flecken bei der Diagnose von kleinen Knoten!
In der Zwischenzeit sollten wir uns alle an eine Sache erinnern:Die Wahrscheinlichkeit, dass ein Lungenknoten bösartig ist, hängt von der Größe des Lungenknotens ab, aber auch von unserem eigenen Alter, der Rauchergeschichte, dem Vorhandensein eines Grats im Knoten und der spezifischen Lage des Knotens.
Derzeit gibt es eine klinische Konsensformel für die Berechnung der Wahrscheinlichkeit einer nodalen Malignität:
Bei <3% ist die Wahrscheinlichkeit gering und die Beobachtung mit Hilfe von Bildgebung die wichtigste Maßnahme; bei 3-68% sind weitere Untersuchungen erforderlich; ab 68% ist eine Biopsie vorzuziehen!
Abschließend noch ein Wort dazu, wie wir kleine Lungenknoten (d.h. solche ohne andere Risikofaktoren für Lungenkrebs) gut untersuchen können: Es ist sehr wichtig, eine Verschlimmerung der Lungenknoten zu verhindern, und das Intervall und die Häufigkeit der Untersuchung richten sich in der Regel nach der Größe des Lungenknotens, und am besten ist es, eine Niedrigdosis-Spiral-CT zu verwenden!
- <4mm kann keine Überprüfung durchgeführt werden, aber wenn Sie unsicher sind, können Sie eine Überprüfung nach 2-3 durchführen;
- 4-6 mm, und nach einem Jahr der Überprüfung kann die Überprüfung abgeschlossen werden, wenn es keine Veränderung gibt;
- 6-8 mm, Überprüfung einmal nach einem halben Jahr und einmal nach einem Jahr, kontinuierliche Überprüfung für zwei Jahre und Beendigung der Überprüfung, wenn keine Anomalien festgestellt wurden;
Vorsicht!Wenn eine Person mit kleinen Lungenknötchen andere Risikofaktoren für Lungenkrebs hat, sollte die Häufigkeit der Nachuntersuchungen von den entsprechenden Zeitintervallen oben erhöht werden!
Da Lungenkrebs im Frühstadium heilbar ist und viele Behandlungen in fortgeschrittenen Stadien unbefriedigend sind, ist das Screening von Lungenknoten wichtig. Die Entdeckungsrate von Lungenknötchen in der Normalbevölkerung ist jedoch sehr hoch! Eine Studie in China ergab, dass etwa 20 % der Normalbevölkerung Lungenknötchen haben, und die meisten davon sind gutartige Knötchen wieEntzündliche Knötchen, Pneumokoniosepartikel, intrapulmonale Lymphknoten, gutartige Tumore, usw.. Deshalb ist es wichtig, die Gut- oder Bösartigkeit von Lungenknoten festzustellen! Man darf nicht zu viele Medikamente verabreichen und gefährliche Knötchen nicht in Ruhe lassen. Wie kann man das wissenschaftlich angehen?
Befolgen Sie zunächst die Leitlinien und suchen Sie nach Lungenknötchen mit hohem Risiko.

Nach den Leitlinien gibt es zwei Arten von Lungenknötchen, die bei der ersten Entdeckung ernst genommen werden sollten:
1. feste Knoten mit einem Durchmesser von mindestens 1,5 cm oder 8-15 mm, aber mit Anzeichen von Bösartigkeit;
2. sub-solide Lungenknötchen mit einem Durchmesser von mehr als 8 mm (gemischte Glasknötchen).

Bei dieser Frau mittleren Alters mit einem 2,2 cm großen Mischmembran-Glasknoten in der linken unteren Lunge handelt es sich beispielsweise um einen Hochrisikoknoten, der in der Tat die klassischen Anzeichen eines Lungenadenokarzinoms aufweist, zu denen gehörenGut ausgeprägter Mattigkeitsschatten mit Gefäßeintritt und Verdickung, bronchiales Insufflationszeichen, distale Pleurabeteiligung, chirurgische Pathologie eines invasiven LungenadenokarzinomsDiese Art von Läsion wird nicht zur Nachsorge empfohlen und sollte zur Abklärung weiter untersucht werden, um eine Metastasierung und eine verzögerte Behandlung zu vermeiden.
Wir müssen jedoch auch erkennen, dass nicht alle Hochrisikoknoten Lungenkrebs sind und dass auch Knoten, die kleiner sind als die oben aufgeführten Hochrisikokriterien, Lungenkrebs sein können! Die Leitlinien sind für uns nur ein Tropfen auf den heißen Stein.
Die Größe des Lungenknotens ist ein wichtiger Referenzindikator

Dieses Bild ist eine Zusammenfassung von Professor Huang vom Shandong Cancer Hospital:
1) Frauen, die Nichtraucherinnen sind, keine Tumore oder chronisch obstruktive Lungenerkrankung oder Fibrose in der Vorgeschichte haben, keine Umweltverschmutzung in ihrem Arbeitsumfeld aufweisen und bei der körperlichen Untersuchung feste Knoten mit einer Größe von weniger als 5 mm feststellen, die grundsätzlich gutartig sind.
2. solide Knötchen, die weniger als 3 cm groß und unter 30 Jahre alt sind, sind überwiegend gutartig, wobei tuberkulöse Knötchen am häufigsten vorkommen.
Durch die beiden oben genannten Untersuchungen sollten Sie ein erstes Verständnis für gutartige Lungenknötchen haben.
Einige Leser werden sich fragen, welche Vorsichtsmaßnahmen zu ergreifen sind, da es sich um eine Zeit handelt, in der die Häufigkeit von Tumoren hoch ist und Lungenkrebs bei jungen Menschen keine Seltenheit ist, sogar einige Lungenadenokarzinome, die kleiner als 0,5 cm sind.
Mikroskopisches Lungenkarzinom bei jungen Menschen ist eine seltene Erkrankung, und kleine Läsionen haben selten eine schlecht differenzierte Komponente, die sicher weiterverfolgt und beobachtet werden kann. Wenn die Läsion während der Nachsorge an Größe oder Dichte zunimmt, ist es noch nicht zu spät für eine Operation.
Es handelt sich um einen Fall in der Literatur, bei dem ein seit sechs Jahren wachsender und immer größer werdender Glasknoten operativ als Adenokarzinom in situ diagnostiziert wurde, das weder metastasiert noch rezidiviert und dessen Entfernung eine Heilung darstellt.
Im Allgemeinen ist es bei einigen sehr kleinen mikroskopischen Lungenkarzinomen, die eine hohe diagnostische Ausrüstung und Technik erfordern, notwendig, dieAnspruchsvolle Beobachtung nach dem Wiederaufbau für mehr DetailsDie Niedrigdosis-Spiral-CT ist nicht in der Lage, diese Art von Präzision zu erreichen.
Die frühe Forschung über Lungenknötchen war in den letzten Jahren sehr gefragt! Das Shanghai East China Hospital, das Zhejiang Zhoushan Hospital, das Shandong Yantaishan Hospital, das Shandong Liaocheng No.2 Hospital und das Hunan Pingjiang County No.1 People's Hospital haben sich auf die Erforschung von Lungenknötchen spezialisiert und konnten hervorragende Forschungsergebnisse vorweisen.
Ich bin Dr. Howe von der Bildgebung. Danke fürs Lesen. Willkommen!
Dies ist eine sehr gute Frage! Mit der rasanten Entwicklung der medizinischen Bildgebungstechnologie, insbesondere der klinischen Anwendung medizinischer CT-Bildgebungsgeräte, werden die Lungenknötchen, die früher nicht erfasst werden konnten, nun unter den "feurigen Augen" der Thorax-CT sichtbar; daher ist die Entdeckungsrate von Lungenknötchen in den heutigen Gesundheitsuntersuchungsberichten überall dort, wo eine Thorax-CT-Untersuchung durchgeführt wird, sehr hoch! Daher ist die Entdeckungsrate von Lungenknötchen in den heutigen Untersuchungsberichten für alle CT-Untersuchungen sehr hoch!
Ist das also eine gute Sache? Oder ist es eine schlechte Sache?
Es ist gut zu sagen, dass es ist, denn nach allem, ein Prozentsatz der Lungenknötchen, kann in Lungenkrebs zu entwickeln, so dass die Erkennung von Lungenknötchen kann als Frühwarnung und Aufmerksamkeit dienen.
Sagen Sie, es ist schlecht, weilLungenknötchen sind schließlich nicht gleichbedeutend mit Lungenkrebs.Daher kann die Entdeckung von Lungenknötchen zu einer zusätzlichen Belastung durch Gedanken und psychischen Stress führen.
Wenn die Großen also diesen technologischen Fortschritt in der Computertomographie nutzen und ihn in einen Vorteil für ihren eigenen Gesundheitsschutz verwandeln wollen, müssen sie ihn verstehen und richtig einschätzenWas kann uns der CT-Befund eines Lungenknotens sagen?
Heute werden wir diese Frage aufgreifen und mit euch darüber sprechen, wie man über Lungenknoten denkt? Welche Art von Lungenknötchen sind nur bösartig? Nur zur Information.
Erstens, ein Wort der Betonung:Ob ein Lungenknoten gefährlich ist, hängt nicht nur davon ab, wie groß er ist, sondern auch davon, wie groß der Lungenknoten istAnzahl, Dichte, Veränderungen und Anzeichen von LungenknötchenEs folgt eine Aufschlüsselung.

1 Blick: Anzahl der Lungenknötchen
Die Anzahl der Lungenknötchen, unterteilt in isolierte Lungenknötchen und multiple Lungenknötchen.
1. isolierte Lungenknötchen:Es handelt sich um eine Art von Lungenknötchen, die eine solitäre Läsion ohne offensichtliche Symptome ist und eine Vielzahl von Ursachen hat, darunter gutartige und bösartige.
2. mehrere Lungenknötchen:Es handelt sich um eine Art von Lungenknoten mit mehr als 2 Herden und ohne offensichtliche Symptome, und die Ursachen sind ebenfalls vielfältig, und es gibt auch gutartige und bösartige.
2 Aussehen: Größe des Lungenknotens
Die Größe eines Lungenknotens wird in der Regel anhand seines Durchmessers gemessen und anhand der Größe des gemessenen Durchmessers grob kategorisiert:
1 Mikromolekül: Durchmesser <5 mm.
2. kleine Knötchen: 5-10 mm im Durchmesser.
3. lungenknoten: Durchmesser ≤30mm.
4. ein Tumor mit einem Durchmesser von ≥ 30 mm.
3 Look: Dichte der Lungenknötchen
Die Dichte der Lungenknötchen ist sogar noch wichtiger als die Größe der Knötchen.
CT-Bilder des Brustkorbs werden nach der Dichte klassifiziert, die sie aufweisen:
1. feste Knötchen2.Partieller fester KnotenGemischte gemahlene Glasdichteknollen; 3.nicht fester Knötchen: Vollständig gemahlene Glasknollen.
Die Dichte dieser drei verschiedenen Arten von Lungenknoten in der CT-Bildgebung ist von großem klinischen Wert für die Bestimmung des gutartigen oder bösartigen Charakters von Lungenknoten in Kombination mit anderen Zeichen.
4 Blick: Veränderungen in Lungenknötchen
Neben der Größe und Dichte der Knötchen sind auch die Veränderungen in den Knötchen, d.h. wie schnell sie wachsen, sehr wichtig.
Es wird allgemein angenommen, dass, wenn die Größe des Lungenknotens nach 3 Monaten, 6 Monaten oder sogar 1 Jahr der Nachuntersuchung seit der Entdeckung des Lungenknotens durch CT unverändert ist oder sogar schrumpft, dies auf eine höhere Wahrscheinlichkeit gutartiger Lungenknoten hinweist.
Wenn sich die Lungenknötchen innerhalb von 3 oder 6 Monaten nach dem CT-Befund vergrößern oder an Größe zunehmen, besteht eine höhere Wahrscheinlichkeit, dass es sich um bösartige Lungenknötchen handelt.
Zusammenfassung:Zusätzlich zu den oben genannten für Lungenknötchen zu:1 Blick auf die Menge, 2 Blick auf die Größe, 3 Blick auf die Dichte, 4 Blick auf die VariationDie "4 Blicke" sollten auch verwendet werden, um anhand der "Zeichen" von Lungenknoten, die als "Lungenknoten" bezeichnet werden, zu bestimmen, ob sie gutartig oder bösartig sind.5 Suchen Sie nach Zeichen", für die im Folgenden Beispiele angeführt werden.

5 Suchen Sie nach einem: Anzeichen für gutartige Lungenknötchen
1. das Tuberkulose-Kugelzeichen:CT-Darstellung: glatte Ränder oder leichte Unregelmäßigkeiten, gleichmäßige oder ungleichmäßige Dichte, häufige Verkalkungen und Satellitenherde.
2. die Anzeichen einer pulmonalen Aspergillose:CT-Erscheinungen: rund oder eiförmig, gleichmäßige Dichte und Trübung, kann einen halbmondförmigen dichten knotigen Schatten aufweisen und ist beweglich.
3. die Anzeichen eines pneumonischen Pseudotumors:Der Patient hat eine Vorgeschichte von Entzündungen, und die CT-Präsentation: rund oder rundlich, mit homogener Dichte und gut definierten Rändern, mit dem typischen Phänomen der Verkalkung und Fettdichte.
4 Anzeichen für gutartige Tumore:CT-Darstellung: glatte, sauber begrenzte Knötchen oder Massenläsionen.
5 Uhr Nr. 2: Anzeichen für bösartige Lungenknötchen
1. die Anzeichen eines Lungenadenokarzinoms:Eine CT des Brustkorbs kann Läsionen in bestimmten Bereichen aufzeigen.
2. feines bronchioloalveoläres Karzinom:CT-Darstellung: runde, ovale oder unregelmäßige knotige Schatten.
3. die Anzeichen von Lungenkrebs:CT-Darstellung: unregelmäßige Läppchen mit ausstrahlenden Graten.
4. die Anzeichen für eine bösartige Metastasierung:CT-Befund: mehrere Knoten in der Lunge, einige wenige sind einzeln, die meisten haben glatte Ränder, wie z. B. metastatische Karzinome der Brust, der Leber, des Choriokarzinoms und des Dickdarms.
Zusammenfassend lässt sich sagen: Bei Lungenknoten geht es nicht nur darum, wie groß sie sind; um festzustellen, ob ein Lungenknoten gefährlich ist, müssen Sie die "5 Blicke" lernen, d. h. 1 die Anzahl, 2 die Größe, 3 die Dichte, 4 die Variabilität und 5 die Zeichen.
Natürlich müssen alle diese Beurteilungen von einem professionellen Kliniker vorgenommen werden.
Sind Sie mit mir einverstanden?
Tägliches Update der Gesundheit Hotspots, medizinische Schmerzpunkte; wenn das, was ich sage, ist genau das, was Sie denken, dann bitte wie, retweet, folgen Zhu Xiaojun sagte Gesundheit!
Besonderer Hinweis: Alle empfohlenen Medikamente im Kommentarbereich sollten mit Vorsicht ausprobiert und nicht auf Zuruf gekauft werden!
Zunächst einmal muss festgestellt werden, dass die meisten Lungenknötchen gutartig sind. Die Frage nach dem Risiko von Lungenknötchen ist vermutlich eine Einschätzung des Risikos der Bösartigkeit von Lungenknötchen. Das Folgende ist eine persönliche Meinung.
Zunächst sollte die Form des Lungenknotens betrachtet werden: Ist der Knoten abgerundet und hat er klare Ränder, ist er in der Regel gutartig; hat er dagegen einen Grat am Rand und unregelmäßige Ränder, sollte er unabhängig von seiner Größe als bösartig angesehen werden.
Natürlich ist auch die Größe des Knotens ein wichtiger Faktor. Im Allgemeinen sollten Sie Ihren Arzt sofort aufsuchen, wenn der Knoten größer als 8 mm ist, vor allem, wenn der Knoten in kurzer Zeit schnell an Größe zunimmt und wenn in Ihrer Familie Rauchen und Lungenkrebs vorkommen.
Bei kleinen Knoten in der Lunge, die kleiner als 8 mm sind, wird eine Nachbeobachtung von etwa 6 Monaten empfohlen.
Schließlich können die folgenden Daten eine erste Vorstellung vom Risiko der Bösartigkeit von Lungenknoten vermitteln: Knoten mit einer Größe von 1 cm haben eine Bösartigkeitswahrscheinlichkeit von etwa 15 %, und Knoten mit einer Größe von 5 mm haben eine Bösartigkeitswahrscheinlichkeit von nur 0,4 %.
Die obige Frage ist meine Antwort. Willkommen zu folgen meine Schlagzeile-Jiangsu Provincial Cancer Hospital Li Feng.
Life Road Public Health ist der Auffassung, dass die Gefahr dieser Lunge Knoten und die Größe der Beziehung, aber nicht eine einzige Größe, um die Gefahr der Norm zu beurteilen, die allgemeine Lunge Knoten in mehr als 1cm kann für die Operation in Betracht gezogen werden, wird gesagt, dass es eine Gefahr für die Möglichkeit der, aber es gibt Knoten, obwohl weniger als 1cm, aber es gibt Lappen, Grate, oder Lungenknötchen in den Blutgefäßen verdreht, oder haben eine feste Komponente, auch wenn weniger als 1cm der Knötchen müssen ebenfalls operiert werden. Es besteht die Möglichkeit einer Bösartigkeit und damit auch eine Gefahr. Der Patient muss nach 3 Monaten, 6 Monaten oder 1 Jahr dynamisch überwacht werden. Wenn sich die Beschaffenheit des Knötchens, seine Form oder seine Wachstumsgeschwindigkeit ändert, ist eine Operation immer noch angebracht.
Lungenknötchen sind kugelförmige Läsionen in der Lunge, die weniger als 3 cm groß sind. Mit dem weit verbreiteten Einsatz der Computertomographie der Brust bei medizinischen Untersuchungen wird die Entdeckungsrate von Lungenknötchen immer höher, und viele Menschen werden auf Lungenknötchen untersucht und sind daher aus Angst vor der Entwicklung und bösartigen Veränderungen alarmiert. Wenn der Lungenknoten größer als 1 cm ist, sollten Sie auf regelmäßige Kontrolluntersuchungen achten. Wenn er nur langsam wächst oder eine glatte Form hat, brauchen Sie sich keine Sorgen zu machen und müssen sich nicht darum kümmern. Da die meisten Knötchen gutartig sind, ist es wichtiger, die Entwicklung der Knötchen zu beobachten.
Life Road öffentlichen Gesundheit Beratung, diese und die übliche Ernährung ah Umwelt hat eine Menge zu tun. In der Regel achten Sie auf die Ernährung von Licht, nicht essen, würzig, fett und süße Lebensmittel sowie. Achten Sie auf die richtige Temperatur, versuchen Sie, sich nicht zu erkälten, geben Sie das Rauchen und den Alkohol auf.
Diese Frage und Antwort sind von den Nutzern der Website, stellt nicht die Position der Website, wenn eine Verletzung, kontaktieren Sie bitte den Administrator zu löschen!